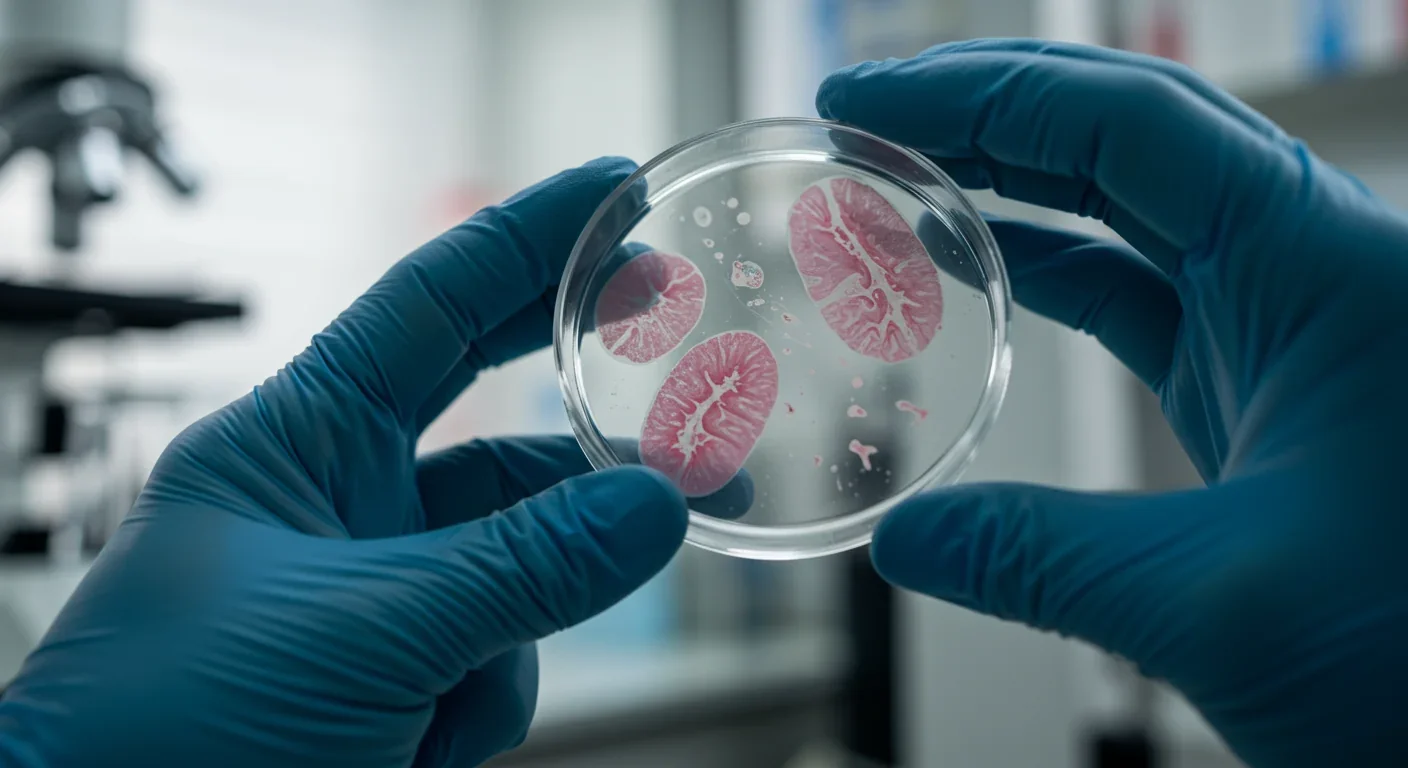
Cricket at water's edge exhibiting suicidal behavior induced by hairworm parasite manipulation

Skunk Cabbage Melts Snow With Its Own Body Heat

TL;DR: Parasites use sophisticated biochemical and neural tactics to hijack host behavior, from zombie ants to human gut microbes altering mood. These manipulation strategies reveal evolution's arms race and have profound implications for neuroscience and medicine.

Imagine a world where your brain isn't entirely your own. Where microscopic invaders can hijack your nervous system, override your survival instincts, and turn you into a puppet dancing to their evolutionary tune. This isn't science fiction - it's happening right now across the animal kingdom, and the mechanisms behind it are rewriting our understanding of behavior, neuroscience, and even human health.
From ants climbing to their deaths on command to crickets committing watery suicide, parasitic manipulation represents one of evolution's most disturbing - and brilliant - innovations. These zombie makers don't just infect their hosts; they fundamentally reprogram them, turning survival instincts inside out to serve a single purpose: ensuring the parasite's next generation.
The most iconic example might be Ophiocordyceps unilateralis, the fungus that transforms carpenter ants into climbing automatons. When fungal spores infiltrate an ant's body, they don't immediately kill. Instead, they grow a network of fungal tubes throughout the ant's muscles, leaving the brain intact but hijacking the central nervous system.
The precision is staggering. The fungus doesn't just make the ant climb - it directs the ant to a location exactly 25 centimeters above ground, on the underside of a north-facing leaf. Scientists discovered this specific spot provides the perfect temperature (25-28°C) and humidity (above 80%) for fungal growth. The ant then clamps its mandibles onto the leaf vein in a death grip so precise it ensures optimal spore dispersal.
"It's a remarkably precise manipulation," explains one mycology researcher. "The fungus knows exactly where it needs to go to ensure its own survival, and it uses the ant as a vehicle to get there. It's a beautiful, brutal example of evolution at work."
What's particularly fascinating: the fungus doesn't directly penetrate the nervous system. Instead, it appears to control the ant's movements by manipulating muscle function via fungal tubes, implying alternative biochemical signaling pathways that influence motor output without direct CNS invasion.
This isn't a singular evolutionary fluke. Approximately 400 species of Cordyceps have been reported, each with highly specific host targeting. Cordyceps sinensis attacks caterpillars, while Cordyceps militaris exclusively targets moths, demonstrating the evolutionary specialization of these parasitic fungi.
While fungal parasites manipulate muscles, other parasites employ more sophisticated biochemical warfare. Hairworms (Nematomorpha) transform crickets into suicidal hosts through a still-mysterious neurochemical process. Infected cricket hosts like Nemobius sylvestris behave erratically, eventually jumping into water when the juvenile worms are ready to emerge - a death sentence for the terrestrial cricket but essential for the aquatic parasite's lifecycle.
The manipulation is so effective that it overrides millions of years of evolved aversion to drowning. The cricket's brain still functions, its survival instincts still exist, but the parasite has inserted itself into the decision-making process at a fundamental neurochemical level.
Even more troubling is the lancet liver fluke Dicrocoelium dendriticum, which orchestrates an elaborate daily cycle in wood ants. Infected ants leave their nests during cool morning hours, ascend flowers, and attach themselves to petals with their mandibles. They remain affixed overnight - prime time for grazing mammals to ingest them - then detach at dawn, descend, and return to the nest. Unless eaten, infected ants repeat this cycle for the entire summer.
Scientists studying this phenomenon discovered something remarkable: 1,349 transcripts are differentially expressed between infected and uninfected ant brains. These genes involve cell signaling pathways for odorant reception, gustatory processing, vision, circadian rhythm, and the production of biogenic monoamines and hormones. The manipulation isn't a simple on-off switch - it's a complex, reversible repertoire of signaling that the parasite orchestrates with precision.
This might all seem like exotic biology confined to insects and fungi, but parasitic manipulation reaches closer to home than most people realize. Blastocystis, a common gut protist that infects humans, has been shown to alter host behavior through serotonin manipulation.
The parasite produces a modified enzyme called BhTnaA that converts indole to tryptophan. Host enterochromaffin cells then use this tryptophan to synthesize serotonin. The result? Mice colonized with Blastocystis display elevated gut tryptophan and serotonin levels that correlate with increased anxiety-like behavior.
In laboratory tests, colonized mice spent 30% less time in lit compartments during anxiety trials compared to controls. The mechanism is clear: parasite-produced tryptophan enables increased serotonin synthesis, which travels via the vagus nerve to influence mood and behavior. Since approximately 90% of human serotonin is produced in the gut, this pathway represents a direct biochemical link between gut parasites and brain function.
The implications are profound. Could parasitic infections contribute to anxiety disorders, irritable bowel syndrome, or other conditions traditionally viewed as purely psychological or dietary? Researchers are exploring whether pharmacological inhibition of the parasite's tryptophanase enzyme could reduce anxiety-like behavior, potentially opening therapeutic strategies for mood disorders.

The existence of such sophisticated manipulation raises an obvious question: why don't hosts evolve defenses? The truth is, they do - constantly. Host-parasite relationships represent one of evolution's most intense arms races.
Inheritance of resistance is under genetic control, and many genes are involved in the response. Selective breeding has produced plant strains resistant to wide varieties of plant diseases, demonstrating that hosts can evolve defenses through genetic mechanisms. The same principle applies to animal hosts, though the multi-gene nature of resistance means protection is rarely absolute.
Parasites counter these defenses through rapid evolution enabled by short generation times and large population sizes. The result is a dynamic equilibrium - a Red Queen's race where both parties must constantly evolve just to maintain their current position.
Some hosts have evolved behavioral defenses. Certain ant species remove infected colony members, reducing transmission. Others alter foraging patterns when parasites are detected in the environment. These social immunity strategies complement individual genetic resistance, creating layered defenses against manipulation.
Parasitic manipulation doesn't just affect individual hosts - it reshapes entire ecosystems. When hairworms force crickets into water, they inject terrestrial biomass into aquatic food webs. Fish and other aquatic predators benefit from this unexpected food source, creating an energy transfer that wouldn't otherwise exist.
Similarly, when Ophiocordyceps kills ants at specific locations, it creates "graveyards" where spores can persist in the environment. These sites become no-go zones for healthy ants, altering colony foraging patterns and potentially affecting seed dispersal, pest control, and other ecosystem services ants provide.
The lancet liver fluke's manipulation creates a bridge between ant colonies, flowers, and grazing mammals - connecting ecological compartments that might otherwise remain separate. This complexity illustrates how parasites can act as keystone species, exerting influence disproportionate to their biomass.
Research also suggests parasites may regulate host population dynamics, preventing any single species from dominating. By preferentially infecting abundant hosts, parasites can maintain biodiversity and ecosystem stability.
Despite decades of research, fundamental questions remain unanswered. What specific molecules do parasites release to hijack host nervous systems? How do they achieve such precision in timing and location? Can hosts ever fully resist manipulation once infected?
The molecular mechanisms remain particularly mysterious. While we know serotonin and other neurotransmitters are involved, identifying the exact proteins, peptides, or small molecules parasites use to control behavior is an ongoing challenge. Many parasites are difficult to culture in laboratories, limiting experimental approaches.
Researchers are also exploring whether host microbiomes influence susceptibility to manipulation. Since gut bacteria produce metabolites that affect behavior, the interaction between parasites, microbiomes, and hosts may be more complex than previously thought.
Perhaps most intriguingly: could understanding parasitic manipulation inform treatment of neurological disorders? If parasites can reprogram behavior through precise biochemical interventions, might we develop similar approaches for conditions like obsessive-compulsive disorder, addiction, or depression?
The study of zombie parasites sits at the intersection of neuroscience, ecology, evolution, and medicine. As techniques improve - from CRISPR gene editing to advanced brain imaging - we're gaining unprecedented insight into these ancient relationships.
Some researchers are exploring biomimicry applications. If fungi can navigate complex environments and execute precise behaviors through chemical signaling, could we develop similar approaches for drug delivery or robotics? Others investigate whether parasitic enzymes might serve as pharmaceutical targets, either to block manipulation or to harness similar pathways therapeutically.
There's also growing recognition that climate change may alter host-parasite dynamics. Temperature and humidity shifts could expand or contract the geographic ranges where manipulation occurs, with unpredictable ecological consequences. Understanding baseline patterns now becomes crucial for predicting future changes.
Parasitic manipulation challenges our assumptions about autonomy, consciousness, and the nature of behavior itself. If a cricket's brain can be overridden by a worm, or an ant's navigation controlled by a fungus, what does that mean for our understanding of free will and decision-making?
These aren't just philosophical questions. They have practical implications for how we approach mental health, infectious disease, and ecosystem management. The boundary between "self" and "other" becomes blurrier when we recognize that microorganisms can fundamentally alter what organisms think, feel, and do.
The zombie parasites reveal a hidden world of manipulation that's been operating for millions of years, refined by evolution into an art form of biochemical puppeteering. As we decode their secrets, we're not just learning about parasites - we're discovering fundamental principles about how nervous systems work, how behavior emerges, and how the microscopic can control the macroscopic.
The next time you make a decision, spare a thought for the possibility that your gut microbiome - including potential parasites - might be weighing in on the choice. Your brain might not be as singular as you think. In nature's grand theater, we're all potential puppets. The question is: who's pulling the strings?

Saturn's moon Titan may harbour liquid water beneath its frozen crust, kept from freezing by ammonia acting as a natural antifreeze. New Cassini data suggests the interior could be slush with warm water pockets rather than a global ocean, and NASA's Dragonfly mission launching in 2028 aims to investigate whether this exotic environment could support life.

The cerebellum, long dismissed as merely a motor coordinator, forms dense circuits with the prefrontal cortex that shape cognition and emotion. Disruption of these pathways is now linked to schizophrenia, autism, and ADHD, opening new frontiers in diagnosis and non-invasive brain stimulation therapies.

Research shows the sharing economy often increases total resource consumption through the Jevons paradox and rebound effects. Ride-sharing adds billions of vehicle miles, co-working spaces use more energy per worker, and diffused responsibility erodes conservation behavior. Breaking the paradox requires congestion pricing, accountability design, and matching sharing models to appropriate resource types.

Illusory superiority causes most people to rate themselves above average in driving, intelligence, and ethics. This bias is rooted in metacognitive blind spots, shaped by culture, and carries real costs in healthcare, finance, and leadership. Structured feedback and institutional safeguards can help, but require ongoing effort.

Eastern skunk cabbage generates its own body heat through the alternative oxidase pathway, maintaining temperatures up to 35°C above freezing air and melting surrounding snow. This thermogenic ability, shared by roughly 90 plant species worldwide, reveals a level of metabolic sophistication that challenges assumptions about plant passivity.

America has 28 vacant homes for every homeless person, yet homelessness hit record highs in 2024. Speculative investment, geographic mismatches, and political barriers explain the paradox, while Finland and Vienna show that Housing First and social housing models can work when the political will exists.

Wafer-on-wafer bonding fuses logic and memory silicon at the atomic level, delivering up to 100x interconnect density over traditional packaging. TSMC, Intel, and Samsung are racing to commercialize the technology as AI chips hit the memory bandwidth wall.